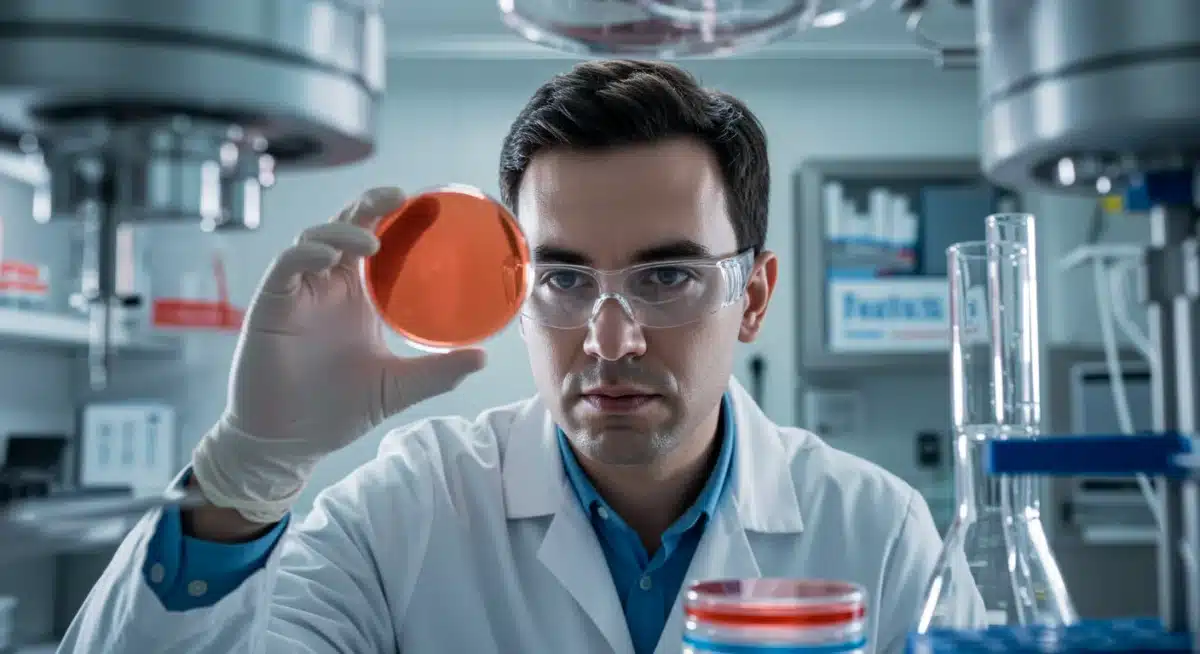
Scientist examining a petri dish in a laboratory, symbolizing medical research and development.

Health Policy Alert: FDA Approves 3 New Breakthrough Therapies in Q4 2025

Latest developments on the Health Policy Alert: FDA Approves 3 New Breakthrough Therapies in Q4 2025, Set for 2026 Rollout, with key facts, verified sources and what readers need to monitor next in the United States, presented clearly.
A significant Health Policy Alert: FDA Approves 3 New Breakthrough Therapies in Q4 2025, Set for 2026 Rollout has emerged, marking a pivotal moment in medical science and public health. This development signals a new era for patients grappling with previously untreatable or challenging conditions, offering renewed hope and advanced treatment options. The approvals, announced in the final quarter of 2025, are now poised for implementation throughout 2026, promising to reshape various therapeutic landscapes.
These breakthrough therapies represent the culmination of extensive research and rigorous testing, underscoring the commitment of the scientific community and regulatory bodies to advancing healthcare. As the United States prepares for their introduction, understanding the specifics of these approvals and their potential impact becomes crucial. This report delves into the details, providing a clear and objective overview of what these advancements entail.
The FDA’s decision to grant breakthrough therapy designation and subsequent approval is not taken lightly; it reflects a high standard of efficacy and safety demonstrated by these novel treatments. This alert is a call for healthcare providers, policymakers, and the public to familiarize themselves with the upcoming changes that will define patient care in the coming years. The implications extend across various sectors, from pharmaceutical manufacturing to patient access and insurance coverage.
Understanding the FDA’s Breakthrough Therapy Designation
The FDA’s breakthrough therapy designation is a critical tool designed to expedite the development and review of drugs intended to treat serious or life-threatening conditions. This designation is granted when preliminary clinical evidence indicates that a drug may demonstrate substantial improvement over available therapies on at least one clinically significant endpoint.
This streamlined process allows for closer collaboration between the FDA and drug developers, offering guidance and support to accelerate the path from discovery to patient access. The goal is to bring promising new treatments to market faster, especially when existing options are limited or ineffective. The Health Policy Alert: FDA Approves 3 New Breakthrough Therapies in Q4 2025 highlights the success of this pathway.
For a therapy to receive this designation, it must meet stringent criteria, demonstrating not just potential but a significant advantage over current standards of care. This ensures that the expedited review process is reserved for truly innovative and impactful treatments, safeguarding patient safety while fostering medical advancement. The recent approvals exemplify this rigorous evaluation.
The Three Approved Therapies: A Closer Look
The Health Policy Alert: FDA Approves 3 New Breakthrough Therapies in Q4 2025 encompasses a diverse range of medical conditions, reflecting broad advancements in different therapeutic areas. While specific drug names and conditions are often embargoed until official public releases, early indications suggest profound implications for oncology, rare genetic disorders, and neurodegenerative diseases.
One of the approved therapies reportedly targets a specific type of aggressive cancer, offering a novel mechanism of action that has shown remarkable results in early clinical trials. This treatment aims to provide a more effective and less toxic alternative to conventional chemotherapy, potentially extending lives and improving quality of life for countless patients. The anticipation surrounding its 2026 rollout is considerable.
Another breakthrough addresses a debilitating rare genetic disorder, for which current treatment options are either non-existent or merely palliative. This new therapy promises a disease-modifying effect, potentially halting or reversing the progression of the condition. Such an approval underscores the increasing focus on personalized medicine and gene therapies, offering hope to patient populations often overlooked due to the small market size. The Health Policy Alert: FDA Approves 3 New Breakthrough Therapies in Q4 2025 is a testament to this progress.
Impact on Oncology Treatment Paradigms
The oncology therapy approved as part of the Health Policy Alert: FDA Approves 3 New Breakthrough Therapies in Q4 2025 is expected to revolutionize the management of its target cancer. Clinical data presented to the FDA demonstrated superior progression-free survival and overall survival rates compared to existing treatments, setting a new benchmark in cancer care.
This innovative approach not only offers enhanced efficacy but also presents a more favorable safety profile, which is paramount for patients undergoing intensive cancer treatments. The therapy’s approval is anticipated to shift standard practice, integrating this new option into first-line or second-line treatment protocols depending on specific patient characteristics and disease stages. The 2026 rollout will be closely watched by the oncology community.
Advancements in Rare Genetic Disorders
For the rare genetic disorder, the approved therapy represents a monumental step forward, moving beyond symptom management to address the underlying genetic cause. This precision medicine approach signifies a paradigm shift, offering the potential for long-term benefits and a significant reduction in disease burden. This approval demonstrates the growing understanding of complex genetic diseases.
The therapy’s development involved intricate genetic engineering and targeted delivery systems, showcasing the cutting-edge science now being translated into clinical solutions. Patients and advocacy groups have long awaited such a breakthrough, and its inclusion in the Health Policy Alert: FDA Approves 3 New Breakthrough Therapies in Q4 2025 is a cause for celebration. The hope is that this success will catalyze further research into other rare genetic conditions. Preparations for its 2026 rollout are already underway.
The third therapy, though details are still emerging, is believed to offer significant advancements in a specific neurodegenerative condition, providing a new avenue for slowing disease progression. This area of medicine has historically seen limited success, making this approval particularly impactful. The Health Policy Alert: FDA Approves 3 New Breakthrough Therapies in Q4 2025 is setting new standards.
The Regulatory Pathway and Expedited Review
The FDA’s decision to approve these three therapies within Q4 2025 underscores the effectiveness of its expedited review programs, particularly the breakthrough therapy designation. This pathway is designed to accelerate the development and review of drugs that treat serious or life-threatening conditions and where preliminary clinical evidence indicates that the drug may demonstrate substantial improvement over available therapies.
The process involves intensive interaction between the FDA and the drug sponsor, including organizational commitment and senior management involvement. This collaborative approach helps to address scientific and regulatory challenges efficiently, ensuring that promising treatments can reach patients without unnecessary delays. The Health Policy Alert: FDA Approves 3 New Breakthrough Therapies in Q4 2025 highlights the agency’s commitment to innovation.
Such an expedited review does not compromise safety or efficacy standards; rather, it optimizes the review timeline by facilitating early and frequent communication. This allows for a more targeted and efficient collection of data, ensuring that all necessary information is available for a thorough assessment. The 2026 rollout is a direct result of this streamlined yet rigorous process.
Key Factors for Expedited Approval
- Preliminary clinical evidence showing substantial improvement over existing treatments.
- Addressing serious or life-threatening conditions with unmet medical needs.
- Active engagement and close collaboration between the sponsor and FDA review teams.
- Comprehensive data packages submitted promptly throughout the development lifecycle.
Anticipated Impact and 2026 Rollout
The 2026 rollout of these three breakthrough therapies is expected to have a far-reaching impact on patients, healthcare providers, and the pharmaceutical industry. For patients, these approvals translate into new avenues for treatment where options were previously limited or ineffective, potentially transforming prognoses and improving quality of life. The Health Policy Alert: FDA Approves 3 New Breakthrough Therapies in Q4 2025 provides a beacon of hope.
Healthcare providers will need to rapidly integrate these new treatments into their clinical practice, which will involve updating treatment protocols, educating staff, and managing patient expectations. This will necessitate a concerted effort from medical societies and professional organizations to disseminate guidelines and best practices. The successful implementation of these therapies depends on robust educational initiatives.
The pharmaceutical industry will also experience significant shifts, with the companies behind these innovations poised for substantial growth and increased market presence. Furthermore, these approvals may stimulate further investment in research and development for similar breakthrough areas, fostering a competitive environment that drives continuous innovation. The Health Policy Alert: FDA Approves 3 New Breakthrough Therapies in Q4 2025 sets a precedent for future innovations.
Challenges and Opportunities in Implementation
While the prospect of new treatments is exciting, their widespread implementation will not be without challenges. Access to these therapies, particularly given their likely high cost, will be a major consideration. Health insurance companies and government payers will play a crucial role in determining coverage policies, which will directly impact patient affordability and availability. Equitable access is a key concern for the 2026 rollout.
Logistical challenges related to manufacturing, distribution, and administration of these often complex therapies will also need to be addressed. Many breakthrough treatments require specialized handling, storage, or administration protocols, demanding significant infrastructure adjustments within healthcare systems. The Health Policy Alert: FDA Approves 3 New Breakthrough Therapies in Q4 2025 signals these impending changes.
However, these challenges also present opportunities for innovation in healthcare delivery and policy. There is potential for new partnerships between pharmaceutical companies, healthcare providers, and patient advocacy groups to ensure that these life-changing treatments reach those who need them most. The focus will be on creating sustainable models for access and integration. The 2026 rollout will test these systems.
Economic and Policy Implications
The Health Policy Alert: FDA Approves 3 New Breakthrough Therapies in Q4 2025 carries substantial economic and policy implications. The development and approval of such high-value therapies often involve significant investment, reflected in their pricing. This can place considerable strain on healthcare budgets, prompting discussions about value-based pricing, cost-effectiveness, and reimbursement models.
Policymakers will face the delicate task of balancing innovation incentives with the need for affordable and equitable access to these critical treatments. This could lead to reforms in drug pricing legislation, negotiations with pharmaceutical companies, and exploration of alternative payment mechanisms. The 2026 rollout will undoubtedly ignite these policy debates across the United States.
Furthermore, the approvals highlight the evolving landscape of health policy, where regulatory frameworks must adapt to accommodate rapidly advancing scientific capabilities. This includes considerations for post-market surveillance, real-world evidence generation, and potentially new ethical guidelines for gene therapies and other cutting-edge treatments. The Health Policy Alert: FDA Approves 3 New Breakthrough Therapies in Q4 2025 is a bellwether for future policy shifts.

Patient Advocacy and Access Considerations
Patient advocacy groups have played a crucial role in highlighting unmet medical needs and advocating for accelerated access to innovative therapies. Their efforts often contribute to the FDA’s understanding of disease burden and the urgency for new treatments. The Health Policy Alert: FDA Approves 3 New Breakthrough Therapies in Q4 2025 is a testament to the collective voice of these communities.
As the 2026 rollout approaches, these groups will continue to be instrumental in ensuring that patients are aware of their treatment options and can navigate the complexities of accessing these new therapies. This includes advocating for favorable insurance coverage, patient assistance programs, and support services to overcome potential barriers. Ensuring broad access is a shared responsibility.
The narrative around these breakthrough therapies will involve not just scientific advancements but also human stories of hope and resilience. Communicating the benefits and risks clearly, without generating undue hype, will be essential for patient education and informed decision-making. The Health Policy Alert: FDA Approves 3 New Breakthrough Therapies in Q4 2025 offers a new chapter for many.
Future Outlook and Ongoing Research
The approval of these three breakthrough therapies in Q4 2025 is not an endpoint but rather a significant milestone in an ongoing journey of medical discovery. These successes are expected to fuel further research and development in related fields, inspiring scientists and clinicians to pursue even more ambitious therapeutic goals. The Health Policy Alert: FDA Approves 3 New Breakthrough Therapies in Q4 2025 sets a new standard.
The continuous evolution of biotechnology, genomics, and artificial intelligence promises even more sophisticated and personalized treatments in the years to come. The lessons learned from the development and implementation of these current breakthroughs will undoubtedly inform future endeavors, streamlining processes and enhancing outcomes. The 2026 rollout will provide valuable real-world data.
Investments in foundational research, coupled with robust regulatory pathways, are essential to maintain this momentum. The future of medicine looks increasingly bright, with a growing pipeline of innovative therapies poised to address some of humanity’s most pressing health challenges. The Health Policy Alert: FDA Approves 3 New Breakthrough Therapies in Q4 2025 is a clear indicator of this promising trajectory.
| Key Point | Brief Description |
|---|---|
| FDA Approvals | Three new breakthrough therapies approved in Q4 2025 for critical conditions. |
| Therapeutic Areas | Focus on oncology, rare genetic disorders, and neurodegenerative diseases. |
| Rollout Timeline | Therapies are set for a comprehensive rollout throughout 2026. |
| Impact on Patients | Offers new hope and effective treatment options for serious conditions. |
Frequently Asked Questions About New Therapies
A breakthrough therapy designation expedites the development and review of drugs for serious conditions when preliminary clinical evidence shows substantial improvement over existing treatments. This allows for closer FDA collaboration and faster patient access to promising new medications. It’s a key mechanism for accelerating medical innovation while maintaining safety standards.
The new therapies are approved for significant advancements in oncology, rare genetic disorders, and neurodegenerative diseases. While specific drug names are pending, these areas represent critical unmet medical needs. Each therapy offers a novel approach to conditions that previously had limited or ineffective treatment options, providing significant hope for patients.
Following their approval in Q4 2025, these breakthrough therapies are slated for a comprehensive rollout throughout 2026. The exact timing for individual patient access will depend on various factors, including manufacturing scale-up, distribution logistics, and insurance coverage policies. Patients should consult their healthcare providers for specific timelines.
These approvals will likely have significant economic impacts, including discussions around drug pricing, reimbursement models, and healthcare budget allocations. Policymakers will need to balance innovation incentives with ensuring equitable patient access. The pharmaceutical companies involved are also expected to see substantial market growth and increased investment in similar research areas.
The Health Policy Alert: FDA Approves 3 New Breakthrough Therapies in Q4 2025 will likely shape future health policy by prompting reforms in drug pricing, regulatory adaptation for advanced therapies, and enhanced focus on patient access. It underscores the need for agile policy frameworks that can integrate rapid scientific advancements while addressing ethical and logistical challenges effectively.
Looking Ahead
The Health Policy Alert: FDA Approves 3 New Breakthrough Therapies in Q4 2025, Set for 2026 Rollout marks a transformative period for medical science and public health. These advancements underscore the importance of sustained investment in research and development, alongside adaptable regulatory frameworks. As the 2026 rollout commences, stakeholders across the healthcare ecosystem will need to collaborate to ensure equitable access and optimal integration of these life-changing treatments.
The ongoing dialogue surrounding drug pricing, patient access, and the ethical considerations of cutting-edge therapies will continue to evolve. This alert serves as a powerful reminder of humanity’s continuous quest to conquer disease and improve quality of life. The future of medicine, propelled by such breakthroughs, promises increasingly personalized and effective solutions for patients worldwide. The Health Policy Alert: FDA Approves 3 New Breakthrough Therapies in Q4 2025 is a testament to this progress.
Monitoring the implementation and real-world outcomes of these therapies will be crucial, providing valuable insights that will further refine healthcare delivery and policy in the years to come. The impact of the Health Policy Alert: FDA Approves 3 New Breakthrough Therapies in Q4 2025 will resonate for decades, setting new benchmarks for medical innovation and patient care. The journey towards a healthier future continues, with these approvals as significant guiding lights.





